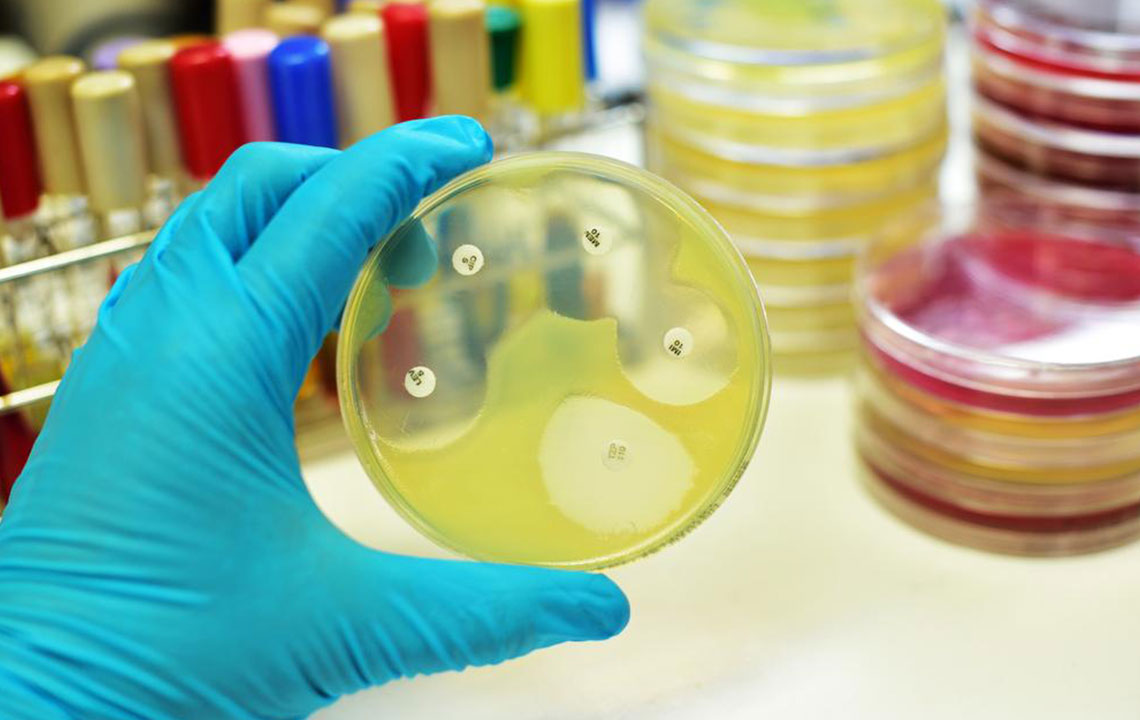
Know about the Different Types of Meningitis and Its Prevention

Know about the Different Types of Meningitis and Its Prevention
The disease meningitis is an ailment where the membrane around the brain and the spinal cord swell due to parasites, fungi or some kind of injury. Meningitis due to viral infections happens to be the most common of all. Bacterial meningitis is an ailment that happens to be more common in young children. Some of the common symptoms of meningitis are fever and headache along with skin rashes. There are different types of meningitis out of which some can be life-threatening as well.
Different types of meningitis-
We now will look at the different types of meningitis cases and will also evaluate on their ratio of being contagious, and then answer the question- is meningitis contagious?
- Fungal Meningitis
As the name suggests, this is a form of meningitis that occurs due to the presence of a fungus called Cryptococcus. This is one of the most uncommon types of meningitis that can strike people with very weak immune systems. This type is not contagious. - Parasitic Meningitis
This is a type of meningitis that can be highly dangerous and even fatal. It is caused due to microscopic amoeba–the Naegleria Fowleri. This is a parasite that enters the body through the nose. It is found in contaminated lakes and rivers. This type of meningitis is not contagious in its nature. - Non-Infectious Meningitis
This is a form of meningitis that could happen due to injuries and brain surgeries. This type of meningitis can yet again happen due to certain types of medication or due to cancer and lupus. As the name suggests, this is a type of meningitis that is not contagious. - Viral Meningitis
It is the most common form of meningitis that is caused by enteroviruses and is contagious in nature. This is a disease that occurs due to direct contact with nasal mucus, saliva or feces. Hence if you are in a direct or an indirect contact with an infected person, then there is every chance that you can get affected by this problem. - Bacterial Meningitis
This form of meningitis can be quite serious and even fatal. It is caused by Neisseria meningitidis or Streptococcus Pneumoniae. Both types are highly contagious. Prolonged exposure to an infected person can increase the chances of getting the disease. This is why schools, colleges, daycares centers, and hostels are likely places where you can catch the disease. It can spread through kissing, sharing of utensils, sneezing, coughing, and through contaminated food.
According to WHO reports there are a large number of people who have bacteria that cause meningitis in their nose and throat without developing the ailment themselves. Yet, they can be a potential risk to others.
The sub-Saharan Africa region has the largest number of meningitis cases registered. Health organizations are of the opinion that children who are below the age of five are the ones who are most vulnerable to the disease. People who are around the age of 60 are the second group who are most in danger of the said disease.
We see that people with a weak immune system are more likely to develop this problem. The incubation period of this disease could be from two to ten days.
Prevention-
The following measures should be followed so that adequate preventive measures can be taken against the dreaded disease:
- Vaccinations for meningitis B and C are a part of childcare that is provided to all. The vaccination for ACWY meningitis is provided to teenagers.
- In case you are planning to visit a part of the world where the disease happens to be common, you must take the advice of a doctor prior to your visit.
- Personal hygiene must be attended to with diligence so that the disease can be prevented.
- In case you know a person who is infected with the disease, it is best that you maintain distance with the person. If anybody in your family has this disease it is best to isolate them to prevent the disease from spreading to the other members of the family.
In case you are infected with the disease contact your doctor quickly. This is the first and best step to a cure for the infection. Make sure that you rush to the emergency room if the symptoms are more severe. Keep a note of all your symptoms and be sure to explain it to the doctor precisely. Talk to your doctor about all possible treatment options after discussing the prognosis. With timely intervention, this disease can be contained without putting you or others in harm’s way.